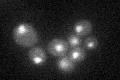
YCR033W
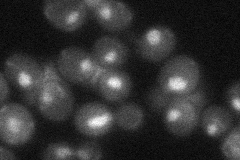
YCR033W
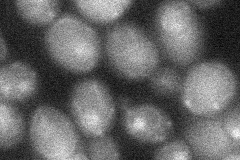
YCR033W
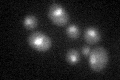
YCR033W
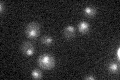
YCR033W

View description
Subunit of the Set3C deacetylase complex that interacts directly with the Set3C subunit, Sif2p; putative DNA-binding protein
Localization:
Intensity:
Fold change:
Significance:
-
C’ GFP library in SD
nucleus23.82 -
N' NOP1pr-GFP in SD

nucleus31.5993 -
N' TEF2pr-mCherry in SD

nucleus16.6607 -
N' NATIVEpr-GFP in SD
nucleus31.0646 -
N' TEF2pr-VC and Cyto-VN in SD
nucleus25.0501 -
C’ GFP library in SD+DTT
nucleus21.310.89No -
C’ GFP library in SD+H2O2

nucleus27.991.17No -
C’ GFP library in Starvation Media
nucleus21.420.89No -
C’ GFP library on the background of Pup2-DaMP

nucleus -
C’ GFP library on the background of CCT mutant

nucleus25.70221.07896No
